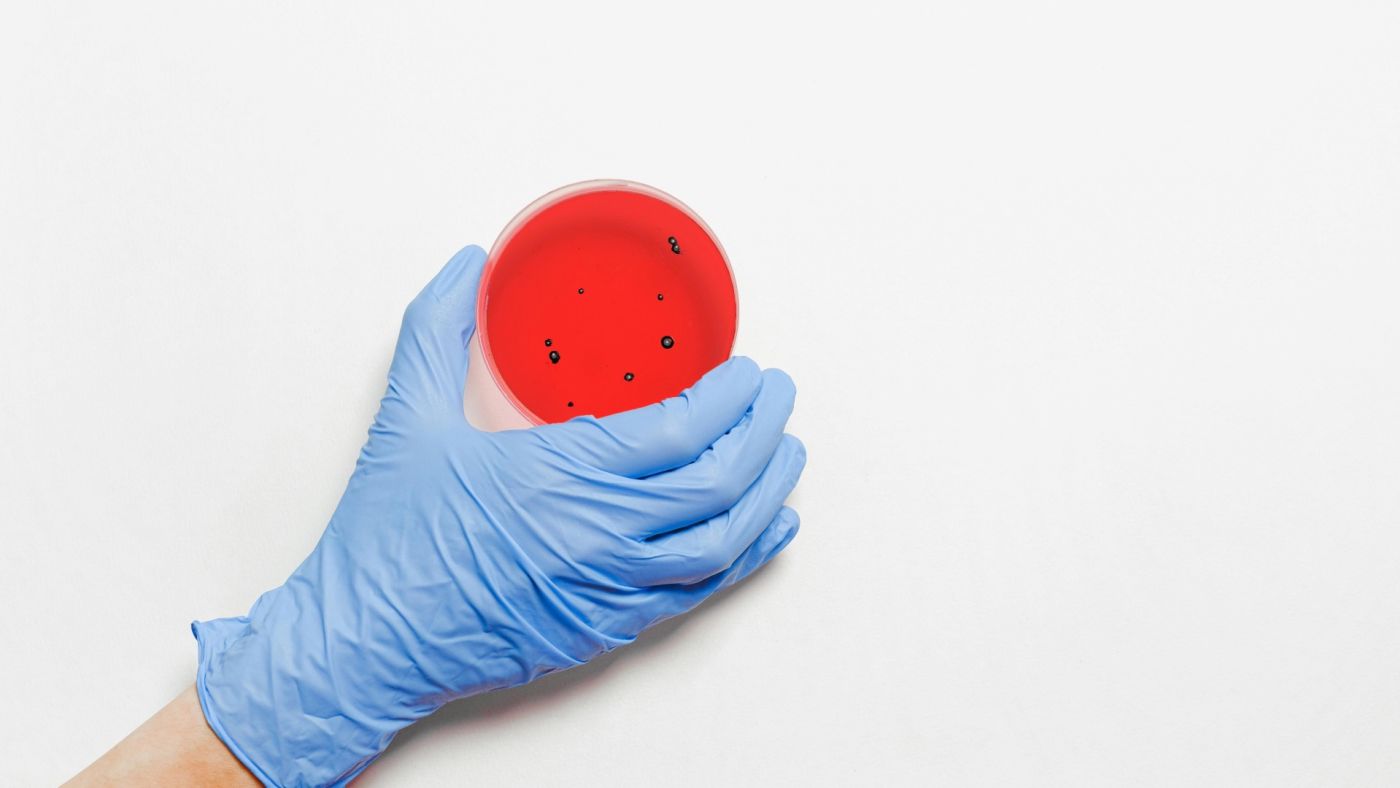
infezioni in aumento negli Stati Uniti

Infezioni in aumento negli Stati Uniti
Gli Stati Uniti stanno affrontando un aumento preoccupante delle infezioni causate da influenza, Covid, RSV (un virus respiratorio che provoca il raffreddore) e norovirus (conosciuto come “influenza intestinale”), proprio mentre milioni di americani tornano al lavoro dopo le festività natalizie. I dati recenti mostrano che tutti e quattro questi virus hanno registrato un’impennata nel periodo delle feste, durante il quale molte famiglie si sono riunite per celebrare.
Il picco delle infezioni è destinato a continuare nelle prossime settimane, con la stagione influenzale che raggiungerà il suo culmine. Secondo i dati, i casi di norovirus sono ai livelli più alti da quando sono iniziati i monitoraggi nel 2012, mentre le ospedalizzazioni per RSV sono aumentate di quasi il 40% in appena due settimane.
Il bilancio delle infezioni
Fino ad oggi, circa 3,1 milioni di persone sono state infettate dall’influenza in questa stagione, con 37.000 ospedalizzazioni e 1.500 decessi. Le statistiche sono preoccupanti, poiché il numero di stati con livelli "molto alti" di influenza è quadruplicato, arrivando a otto. Allo stesso tempo, tra il 1° ottobre e il 7 dicembre, si stima che tra 2,5 e 4,4 milioni di americani siano stati colpiti dal Covid, con circa 72.000-120.000 ospedalizzazioni e tra 8.200 e 13.000 morti.
Le misure di contenimento
L'aumento delle infezioni ha spinto alcuni stati a reintrodurre l’obbligo di indossare la mascherina. È il caso, ad esempio, del sistema sanitario Aurora Health Care in Wisconsin, che ha annunciato il ritorno delle mascherine per pazienti e visitatori. Allo stesso modo, in alcune zone della California, Illinois, Indiana e New Jersey, gli ospedali hanno reintrodotto le regole per il personale e i visitatori. Le autorità sanitarie di New York City hanno anche esortato i cittadini a prendere in considerazione l’uso della mascherina sui mezzi pubblici. Gli esperti spiegano che la diffusione dei virus è stata favorita dalla maggiore socializzazione durante le festività e dai viaggi sui mezzi pubblici e sugli aerei.
Inoltre, il contesto di fragilità sanitaria lasciato dalla Pandemia di Covid, che ha indebolito il sistema immunitario di molte persone a causa dei lockdown e delle restrizioni sul lavoro da casa, rende più vulnerabili a malattie gravi.
Le previsioni per le prossime settimane
Il dottor Joe Bresee, esperto di malattie infettive ed ex membro dei CDC, ha dichiarato che l'aumento delle malattie respiratorie e del norovirus è una situazione che si ripete ogni anno, ma che le cifre continueranno a salire nei prossimi giorni. “Sarà un picco che arriverà tra gennaio e febbraio, ma varierà a seconda delle diverse regioni del paese”, ha spiegato l’esperto.
Inoltre, il dottor Todd Rice, professore di medicina in Tennessee, ha sottolineato che le persone che trascorrono del tempo in ambienti chiusi e affollati sono più esposte alla diffusione dei virus. Le previsioni suggeriscono che il numero di casi rimarrà elevato ancora per almeno una o due settimane.
RSV e norovirus: due malattie sotto osservazione
L'RSV ha visto un aumento significativo di ospedalizzazioni, con circa 22.000-45.000 ricoveri da ottobre, e tra 980 e 2.300 decessi. Il tasso di ospedalizzazione è aumentato del 40%, passando da 1,3 a 1,8 per 100.000 abitanti in appena due settimane. Nel frattempo, il norovirus ha registrato un numero record di focolai, con oltre 90 episodi segnalati nella prima settimana di dicembre, tre volte rispetto alle due settimane precedenti. Questa impennata è stata in parte legata a un focolaio a Los Angeles, dove almeno 80 persone si sono ammalate dopo aver mangiato ostriche crude contaminate al norovirus.
Come prevenire l’infezione?
Gli esperti consigliano di adottare misure precauzionali per limitare la diffusione dei virus, tra cui il lavaggio frequente delle mani, coprire bocca e naso quando si tossisce o starnutisce, e restare a casa in caso di malattia. Il CDC raccomanda anche la vaccinazione contro l'influenza e il Covid, in particolare per le persone a partire dai sei mesi di età, e per gli over 75 contro l'RSV.
Inoltre, la vaccinazione è fondamentale per prevenire complicazioni più gravi. Sebbene non esista un trattamento specifico per il Covid, l'influenza e l'RSV, questi virus possono essere trattati con farmaci antivirali e analgesici per alleviare i sintomi. I medici raccomandano di recarsi al pronto soccorso se i sintomi diventano gravi.
Con l'inverno ormai in pieno svolgimento, gli Stati Uniti si trovano a fronteggiare una combinazione di virus che mettono sotto pressione il sistema sanitario, già impegnato a gestire l'epidemia di Covid. Le prossime settimane saranno decisive per capire come evolverà la situazione, con gli esperti che si preparano a monitorare attentamente la curva delle infezioni, soprattutto in vista del picco influenzale.


